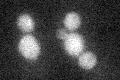
YBL016W
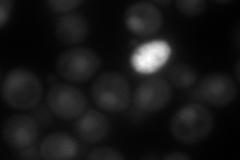
YBL016W

View description
Mitogen-activated serine/threonine protein kinase involved in mating; phosphoactivated by Ste7p; substrates include Ste12p, Far1p, Bni1p, Sst2p; inhibits invasive growth during mating by phosphorylating Tec1p, promoting its degradation
Localization:
Intensity:
Fold change:
Significance:
-
C’ GFP library in SD
below threshold16.87 -
N' NOP1pr-GFP in SD

cytosol,nucleus67.156 -
N' TEF2pr-mCherry in SD
nucleus127.687 -
N' NATIVEpr-GFP in SD

nucleus48.6182 -
N' TEF2pr-VC and Cyto-VN in SD

#N/A0 -
C’ GFP library in SD+DTT

cytosol16.891No -
C’ GFP library in SD+H2O2

cytosol16.770.99No -
C’ GFP library in Starvation Media

cytosol23.471.39No -
C’ GFP library on the background of Pup2-DaMP

below threshold -
C’ GFP library on the background of CCT mutant

below threshold17.09961.01322No
